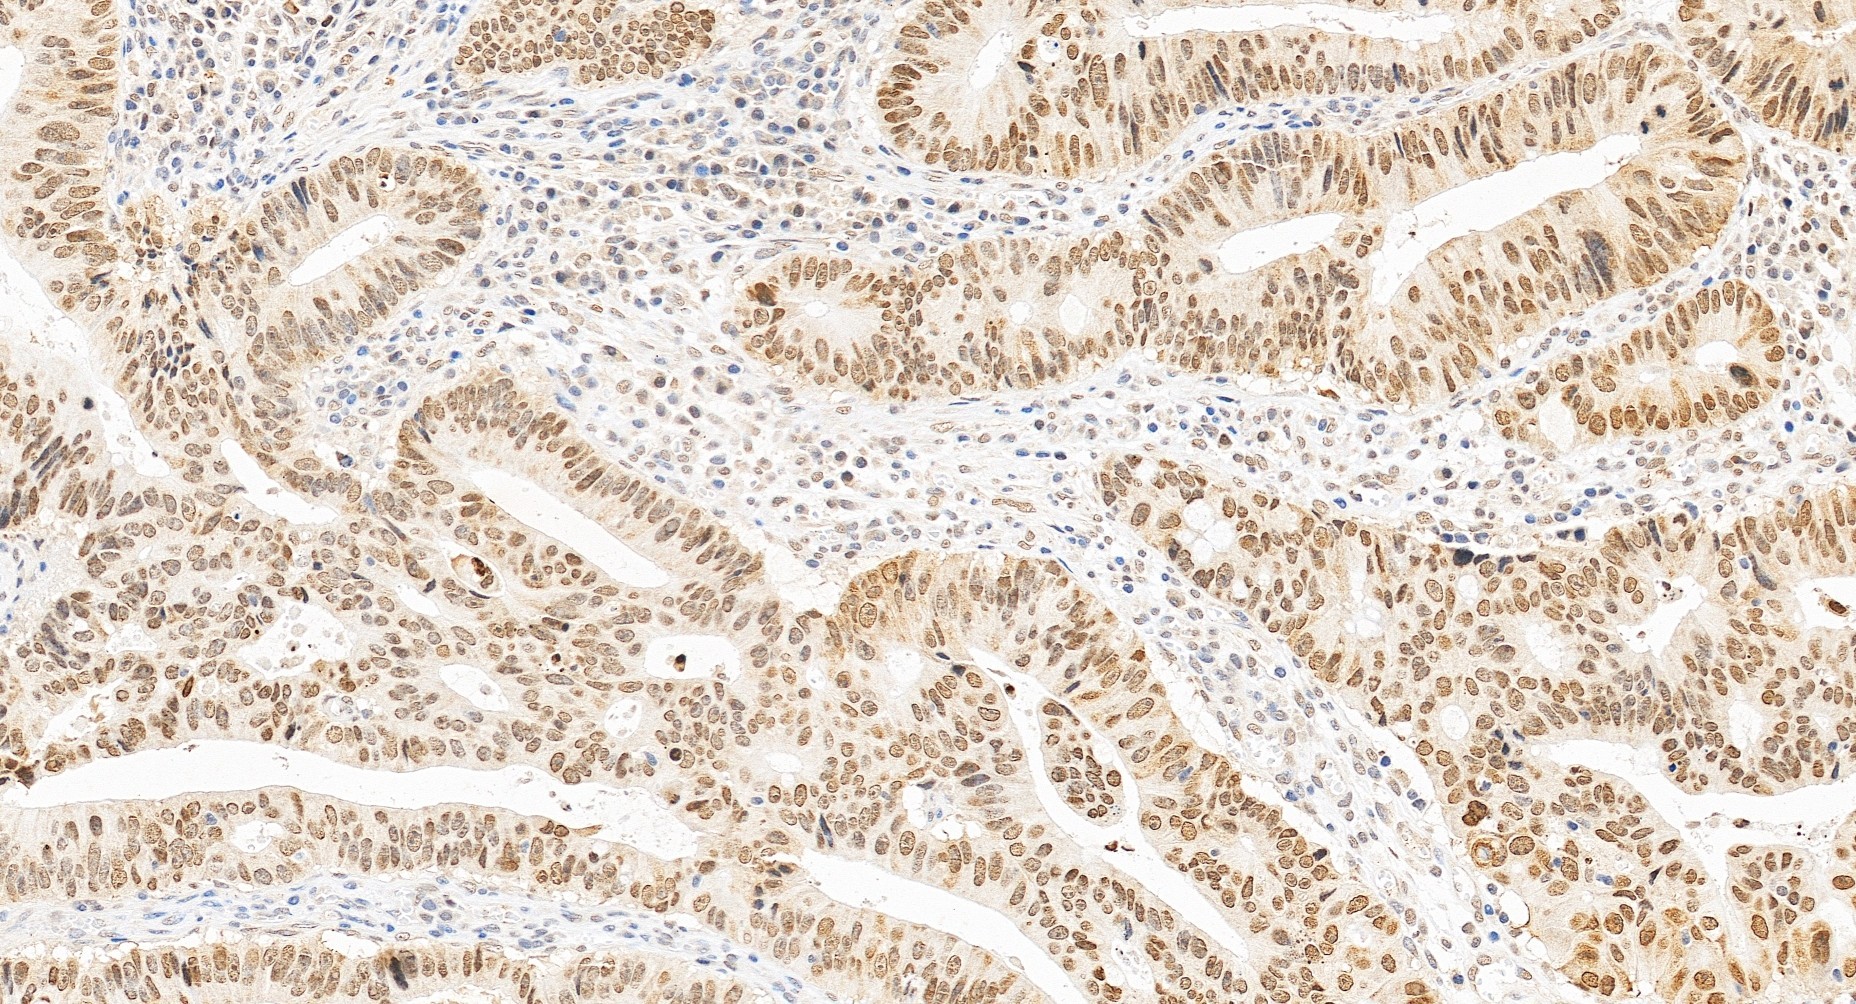

验证数据展示
经过测试的应用
| Positive WB detected in | A549 cells, HCT 116 cells, HepG2 cells, NCI-H1299 cells, NIH/3T3 cells, C6 cells |
| Positive IP detected in | NIH/3T3 cells |
| Positive IHC detected in | human pancreas cancer tissue, human colon cancer tissue Note: suggested antigen retrieval with TE buffer pH 9.0; (*) Alternatively, antigen retrieval may be performed with citrate buffer pH 6.0 |
| Positive IF/ICC detected in | A549 cells, HepG2 cells |
推荐稀释比
| 应用 | 推荐稀释比 |
|---|---|
| Western Blot (WB) | WB : 1:5000-1:50000 |
| Immunoprecipitation (IP) | IP : 0.5-4.0 ug for 1.0-3.0 mg of total protein lysate |
| Immunohistochemistry (IHC) | IHC : 1:250-1:1000 |
| Immunofluorescence (IF)/ICC | IF/ICC : 1:50-1:500 |
| It is recommended that this reagent should be titrated in each testing system to obtain optimal results. | |
| Sample-dependent, Check data in validation data gallery. | |
产品信息
20795-1-AP targets HMGA2 in WB, IHC, IF/ICC, IP, CoIP, ELISA applications and shows reactivity with human, mouse, rat samples.
| 经测试应用 | WB, IHC, IF/ICC, IP, ELISA Application Description |
| 文献引用应用 | WB, IHC, IF, IP, CoIP |
| 经测试反应性 | human, mouse, rat |
| 文献引用反应性 | human, mouse, rat |
| 免疫原 |
CatNo: Ag14588 Product name: Recombinant human HMGA2 protein Source: e coli.-derived, PGEX-4T Tag: GST Domain: 1-109 aa of NM_003483 Sequence: MSARGEGAGQPSTSAQGQPAAPAPQKRGRGRPRKQQQEPTGEPSPKRPRGRPKGSKNKSPSKAAQKKAEATGEKRPRGRPRKWPQQVVQKKPAQEETEETSSQESAEED 种属同源性预测 |
| 宿主/亚型 | Rabbit / IgG |
| 抗体类别 | Polyclonal |
| 产品类型 | Antibody |
| 全称 | high mobility group AT-hook 2 |
| 别名 | High mobility group AT-hook protein 2, High mobility group protein HMGI-C, HMGI C, HMGIC |
| 计算分子量 | 108 aa, 12 kDa |
| 观测分子量 | 18-20 kDa |
| GenBank蛋白编号 | NM_003483 |
| 基因名称 | HMGA2 |
| Gene ID (NCBI) | 8091 |
| RRID | AB_2665377 |
| 偶联类型 | Unconjugated |
| 形式 | Liquid |
| 纯化方式 | Antigen affinity purification |
| UNIPROT ID | P52926 |
| 储存缓冲液 | PBS with 0.02% sodium azide and 50% glycerol, pH 7.3. |
| 储存条件 | Store at -20°C. Stable for one year after shipment. Aliquoting is unnecessary for -20oC storage. |
背景介绍
HMGA2 belongs to the family of high mobility group with AT-hook DNA binding domain. HMGA proteins are considered architectural transcription factors; they do not have direct transcriptional activation capacity, but instead regulate gene expression by changing DNA conformation through binding to AT-rich regions in the DNA and/or direct interaction with other transcription factors (PMID: 18202751,19551524). HMGA2 is abundantly and ubiquitously expressed and plays a crucial role during embryonic development (18425117). HMGA2 promotes stem cell self-renewal and research studies have shown that decreased HMGA2 expression is associated with stem cell aging (19551524). Investigators have shown that expression levels of HMGA2 are very low in normal adult tissues, while either overexpression or rearrangement is associated with many types of cancer (PMID: 20228781). The calcualted molecular weight of HMGA2 is 12 kDa, but modified HMGA2 is about 18-20 kDa. (PMID: 18505920 )
实验方案
| Product Specific Protocols | |
|---|---|
| IF protocol for HMGA2 antibody 20795-1-AP | Download protocol |
| IHC protocol for HMGA2 antibody 20795-1-AP | Download protocol |
| IP protocol for HMGA2 antibody 20795-1-AP | Download protocol |
| WB protocol for HMGA2 antibody 20795-1-AP | Download protocol |
| Standard Protocols | |
|---|---|
| Click here to view our Standard Protocols |
发表文章
| Species | Application | Title |
|---|---|---|
Acta Pharm Sin B Blockade of the deubiquitinating enzyme USP48 degrades oncogenic HMGA2 and inhibits colorectal cancer invasion and metastasis | ||
Nat Commun ICAM1 initiates CTC cluster formation and trans-endothelial migration in lung metastasis of breast cancer. | ||
Nat Commun N6-methyladenosine modification of circNSUN2 facilitates cytoplasmic export and stabilizes HMGA2 to promote colorectal liver metastasis. | ||
Cancer Res Pooled CRISPR Screening Identifies P-Bodies as Repressors of Cancer Epithelial-Mesenchymal Transition | ||
ACS Appl Mater Interfaces Layered Double Hydroxide Nanoparticles with Osteogenic Effects as miRNA Carriers to Synergistically Promote Osteogenesis of MSCs. |